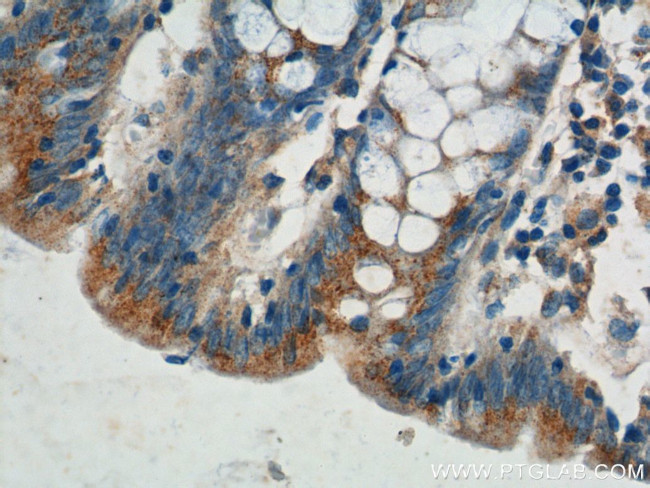
Plakophilin 3 Antibody in Immunohistochemistry (Paraffin) (IHC (P))

Search
Proteintech
Plakophilin 3 Polyclonal Antibody
{{$productOrderCtrl.translations['antibody.pdp.commerceCard.promotion.promotions']}}
{{$productOrderCtrl.translations['antibody.pdp.commerceCard.promotion.viewpromo']}}
{{$productOrderCtrl.translations['antibody.pdp.commerceCard.promotion.promocode']}}: {{promo.promoCode}} {{promo.promoTitle}} {{promo.promoDescription}}. {{$productOrderCtrl.translations['antibody.pdp.commerceCard.promotion.learnmore']}}
产品信息
18338-1-AP
种属反应
宿主/亚型
分类
类型
抗原
偶联物
形式
浓度
规格
纯化类型
保存液
内含物
保存条件
运输条件
产品详细信息
Immunogen sequence: VGSRADYDT LSLRSLRLGP GGLDDRYSLV SEQLEPAATS TYRAFAYERQ ASSSSSRAGG LDWPEATEVS PSRTIRAPAV RTLQRFQSSH RSRGVGGAVP GAVLEPVARA PSVRSLSLSL ADSGHLPDVH GFNSYGSHRT LQRLSSGFDD IDLPSAVKYL MASDPNLQVL GAAYIQHKCY SDAAAKKQAR SLQAVPRLVK LFNHANQEVQ RHATGAMRNL IYDNADNKLA LV (170-400 aa encoded by BC000081)
靶标信息
Plakophilin-3 is an Armadillo-like protein present in nuclei and desmosomes of epithelial cells. The expression pattern of this protein seems to be largely restricted to epithelial cell types. Plakophilin-3 can be detected along cell borders in a punctuate staining pattern typical for desmosomal proteins. In addition to the desmosomal immunolocalization, immunostaining was observed as bright nuclear speckles. Thus, like plakophilin-1 and-2, plakophilin-3 displays a dual intracellular localization in the desmosomal plaque and in the cell nucleus, and therefore is probably involved in signal transduction pathways between the plasma membrane and the nucleus. The human protein has a predicted molecular mass of ~87 kDa.
仅用于科研。不用于诊断过程。未经明确授权不得转售。
篇参考文献 (0)
生物信息学
蛋白别名: armadillo protein; plakophilin 3b; Plakophilin-3
基因别名: 2310056L12Rik; PKP3
UniProt ID: (Human) Q9Y446, (Mouse) Q9QY23
Entrez Gene ID: (Human) 11187, (Mouse) 56460, (Rat) 293619